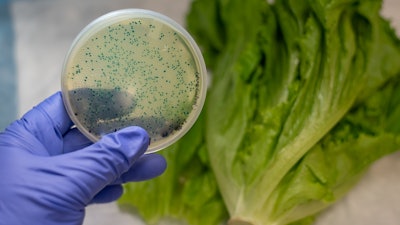

Recommendation
FDA, CDC, and state health authorities are investigating an outbreak of illnesses caused by E. coli O157:H7 in the United States. Epidemiologic, laboratory and traceback evidence indicates that romaine lettuce from the Salinas, CA growing region is a likely source of this outbreak. According to CDC, there have been 102 cases reported in 23 states. The latest date that one of these patients reports becoming ill was on Nov. 18.
Consumers: Consumers should not eat romaine lettuce harvested from Salinas, California. Additionally, consumers should not eat products identified in the recall announced by the USDA on Nov. 21.
Romaine lettuce may be voluntarily labeled with a harvest region. If this voluntary label indicates that the romaine lettuce was grown in “Salinas” (whether alone or with the name of another location) do not eat it. Throw it away or return it to the place of purchase. If romaine lettuce does not have information about harvest region or does not indicate that it has been grown indoors (i.e., hydroponically- and greenhouse-grown), throw it away or return it to the place of purchase. Consumers ordering salad containing romaine at a restaurant or at a salad bar should ask the staff whether the romaine came from Salinas. If it did, or they do not know, do not eat it.
At this time, romaine lettuce that was harvested outside of the Salinas region has not been implicated in this outbreak investigation. Hydroponically- and greenhouse-grown romaine, which is voluntarily labeled as “indoor grown,” from any region does not appear to be related to the current outbreak. There is no recommendation for consumers to avoid using romaine harvested from these other sources.
Restaurants and Retailers: Restaurants and retailers should not serve or sell romaine harvested from Salinas, California. If you do not know the source of your romaine lettuce, and if you cannot obtain that information from your supplier, you should not serve, nor sell it.
Suppliers and Distributors: Suppliers, distributors and others in the supply chain should not ship or sell romaine harvested in Salinas, California. If the source of the romaine lettuce is unknown, you should not ship, nor sell the product.
For Restaurants, Retailers, Suppliers and Distributors: Currently, the FDA does not have enough traceback information to identify the specific source of the contamination that would allow us to request a targeted recall from specific growers.
FDA requested that industry voluntarily withdraw romaine grown in Salinas from the market and is requesting that industry withhold distribution of Salinas romaine for the remainder of the growing season in Salinas. Without more specific traceback information, this was the most efficient way to ensure that contaminated romaine was off the market.
At this time, romaine lettuce that was harvested outside of the Salinas region has not been implicated in this outbreak investigation. Hydroponically- and greenhouse-grown romaine, which is voluntarily labeled as “indoor grown,” from any region does not appear to be related to the current outbreak. There is no recommendation for consumers or retailers to avoid using romaine harvested from these other sources.
Update
Based on the information indicating that ill people in Maryland were exposed to romaine lettuce harvested in Salinas, CA, FDA, with the assistance of staff from the California Department of Public Health and the California Department of Food and Agriculture, immediately deployed investigators to three farms in the Salinas area that were identified based on the traceback investigation.
FDA continues to actively investigate the cause of this outbreak. Additionally, FDA is investigating two other E. coli outbreaks, each caused by strains that are different from each other and different from the larger outbreak. One of the additional outbreaks, in Washington state, is linked to romaine lettuce, and the other outbreak, with cases in the U.S. and Canada, is linked to Fresh Express Sunflower Crisp Chopped Salad Kits. As part of these investigations, FDA and state partners are conducting traceback investigations to trace romaine exposures to the source.
Currently, the tracebacks on all three outbreaks have identified a common grower in Salinas. FDA, CDC, and California partners are deploying a team to conduct new investigations at several ranches used by this grower as we try to identify the source of the contamination.